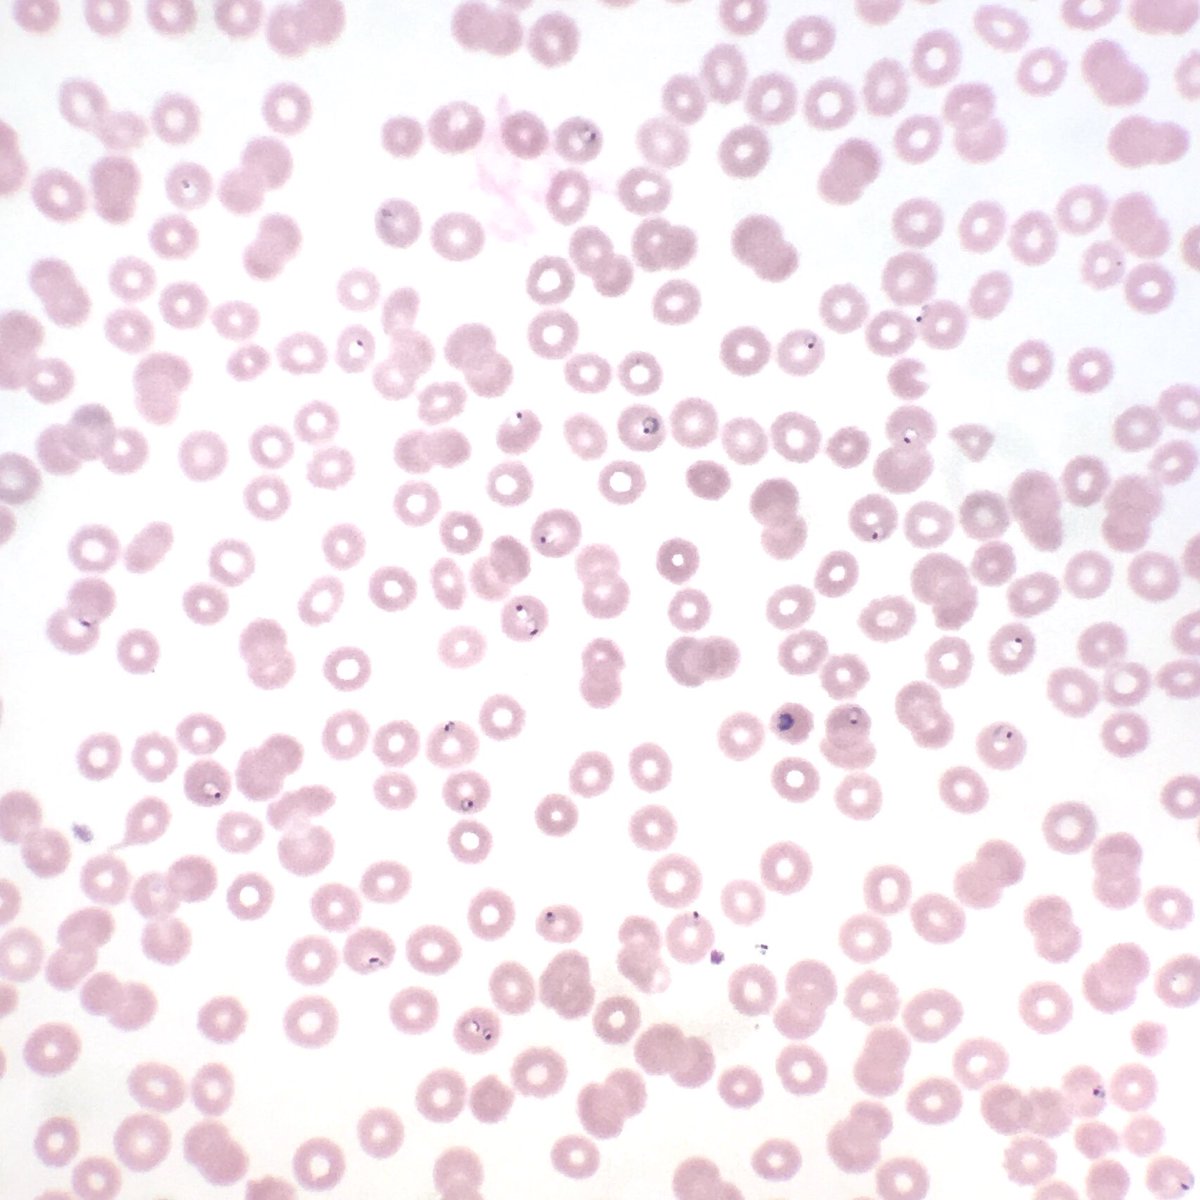
MFeelyDO's tweet image. Really enjoyed listening to the recording of @ParasiteGal’s #CAPVirtualPath lecture. I even dug out my secret stash of peripheral smears.

Michael Feely, DO
@MFeelyDO
Gastrointestinal and Liver Pathologist at University of Florida
You might like
Interested in the crossroads of pediatric and adult GI pathology? Members can join us today at 12:00 PM EST for a free e-Learning forum. Please see the details below! #GIPS #GIpath #pathology

What do all of these beautiful cases have in common besides being found in the most exciting organ system of the body? They have all been featured as one of our Cases of the Month! Interested in sharing a case with a worldwide audience? 👀⬇️ #GIPS #GIpath




Polypoid lesion of sigmoid colon. Not a frequently seen one 🙃 #PathTwitter #GIpath #BeautyInBenign




UF has the highest 1y liver graft survival in US. HR of graft loss is 75% lower than the American average. Heavy work by many people and reason of great honor for us. Could not be prouder of the team! Gators strong! 🐊@UF @UFHealth @UFSurgery @ASTSChimera #livertwitter

Another one for the bucket list. Beautiful case of an alien invader.
Any thoughts on this beautiful, elegant creature that "crawled" into the colonic mucosa and presented as polyp !! I have been googling it for ages and can't find a morphologic fit with any of the adult/ larval parasitic forms that I have ever encountered. Pt is asymptomatic.



Finally watching the last season of #SchittsCreek so I figured I’d share these appropriately themed snapshots. Look mom, no eggs! #parasite #pathology


Beautiful surgical pathology case. And here you thought egg ID only comes in handy in CP.
The Parasite Case of the Week 608 is up – Eggs found in the intestine – what are they? See the case here: parasitewonders.blogspot.com/2020/09/case-o… #asmclinmicro #MayoClinMicro #mayopath #parasites #pathology @JMGardnerMD @mayocliniclabs @ASTMH @Pathologists @AmSocParasit @LSHTM #path2path

Candida in esophageal biopsies should always be considered to be possibly clinically significant and the presence of neutrophilic inflammation and tissue invasion are not required to establish a diagnosis of fungal infection. #GIPSJournalWatch pubmed.ncbi.nlm.nih.gov/31944368/
And here we get all worked up when a solitary one shows up! Here’s my best attempt at a photo under the dissecting scope of a recent visitor.

One video from my archives. An 8y child was refd for sigmoidoscopy from a pediatric unit. 3 mth Hx of dysentery, anaemia and stunting. We put the scope in and look what we found! #MedTwitter #MedEd #Gigang #endoscopy
There’s a lot of terrible news in the world right now so I thought you’d like to know that someone’s cancer just completely vanished.
CMV fiesta!
Really enjoyed listening to the recording of @ParasiteGal’s #CAPVirtualPath lecture. I even dug out my secret stash of peripheral smears.

United States Trends
- 1. $GHOST N/A
- 2. Good Thursday N/A
- 3. Board of Peace N/A
- 4. Osaka N/A
- 5. Happy Friday Eve N/A
- 6. #MIKIMOTOSGxFreen N/A
- 7. SAROCHA AT MIKIMOTO SG OPENING N/A
- 8. Happy Birthday Amy N/A
- 9. Rafael Tudares N/A
- 10. #thursdayvibes N/A
- 11. #DareYouToDeathEP5 N/A
- 12. #Haus64xPLingNNoey N/A
- 13. HAUS64 LINGLING NND PARTY N/A
- 14. #ThursdayMotivation N/A
- 15. Gavin N/A
- 16. Cuomo N/A
- 17. Zac Robinson N/A
- 18. Cirstea N/A
- 19. Fredo N/A
- 20. Jack Smith N/A
You might like
-
 Maryam Pezhouh, MD, MS
Maryam Pezhouh, MD, MS
@pezhouh -
 Andres Matoso
Andres Matoso
@Andres_Matoso -
 Michael Arnold, MD, PhD
Michael Arnold, MD, PhD
@MArnold_PedPath -
 Laura Collins
Laura Collins
@CollinsLauraC -
 John Hart, MD
John Hart, MD
@johnhart20 -
 GIPS (GI Pathology Society)
GIPS (GI Pathology Society)
@USGIPS -
 Wendy Frankel, MD
Wendy Frankel, MD
@WendyFrankelMD -
 Rhonda Yantiss
Rhonda Yantiss
@RhondaYantiss -
 Emma Elizabeth Furth
Emma Elizabeth Furth
@emma_furth -
 Mario Prieto MD PhD
Mario Prieto MD PhD
@dr_MPrieto -
 Ted Farzaneh, MD
Ted Farzaneh, MD
@TedFarMD -
 Yale Rosen
Yale Rosen
@yro854 -
 E. Heidi Cheek, MHS, PA(ASCP)
E. Heidi Cheek, MHS, PA(ASCP)
@E_Heidi_Cheek -
 Yasmeen M. Butt
Yasmeen M. Butt
@YasmeenButtMD -
 Pallavi A. Patil, MD
Pallavi A. Patil, MD
@PAPatilMD
Something went wrong.
Something went wrong.










































































































































